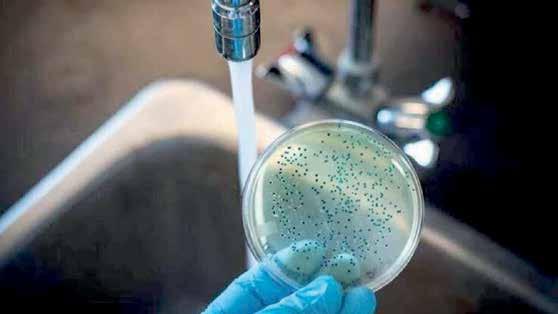

AL

AÑO XVIIIVIERNES 7 OCTUBRE 2022 NO. 3841 Circulación Nacional SUPERA EDOMÉX REGRESO PRESENCIAL ANTE PANDEMIA PREPA 2 DE LA UAEMÉX ESTRENA SISTEMA DE CAPTACIÓN Y FILTRACIÓN DE AGUA PLUVIAL SHEINBAUM ENCABEZA INICIO DE ESTRATEGIA “ZARAGOZA SEGURA” CLOUTHIER NIEGA SALIDA “ABRUPTA” DEL GOBIERNO; RENUNCIÓ EL 26 DE JULIO PÁG. 7 PÁG. 14 EDOMÉX UAEMÉX CDMX PÁG. 10 INFORMES DE LA SEDENA Y LA MARINA FILTRADOS POR EL COLECTIVO GUACAMAYA VINCULAN AL CÍRCULO CERCANO DE CUAUHTÉMOC BLANCO, A GRACO RAMÍREZ, SENADORES, DIPUTADOS, ALCALDES Y JUECES CON GRUPOS DEL NARCOTRÁFICO COMO EL CJNG, LOS ROJOS Y GUERREROS UNIDOS. PÁG. 15 JARED LETO HARÁ PELÍCULA BIOGRÁFICA DE KARL LAGERFELD GOBERNADORES, SENADORES, DIPUTADOS
MORELOS LIGADOS
NARCO
Uriel Carmona Gándara
Samuel Sotelo Salgado Alfonso de Jesús Sotelo Ángel García Yáñez
Cuauhtémoc Blanco Graco Ramírez
José Manuel Sanz Rivera José de Jesús Guizar


@ElInformanteMX elinformante.mx Viernes 7 Octubre 2022 editorial


elinformante.mxViernes 7 Octubre 2022 nacional


@ElInformanteMX elinformante.mx Viernes 7 Octubre 2022 nacional



elinformante.mxViernes 7 Octubre 2022 cdmx


elinformante.mx Viernes 7 Octubre 2022 cdmx @ElInformanteMX



elinformante.mxViernes 7 Octubre 2022 edomex



@ElInformanteMX El Informante México USA elinformante.mx Viernes 7 Octubre 2022 principal









@ElInformanteUSEl Informante México elinformante.mxViernes 7 Octubre 2022 portada



@ElInformanteMX El Informante México USA elinformante.mx Viernes 7 Octubre 2022 edomex


@ElInformanteUSEl Informante México elinformante.mx municipios Viernes 7 Octubre 2022





@ElInformanteMX El Informante México USA elinformante.mx Viernes 7 Octubre 2022 municipios


@ElInformanteUSEl Informante México elinformante.mx municipios Viernes 7 Octubre 2022





@ElInformanteMX El Informante México USA elinformante.mx Viernes 7 Octubre 2022 deportes




@ElInformanteUSEl Informante México elinformante.mx espectáculos Viernes 7 Octubre 2022


Coordinador de Reporteros, y Editor de la Edición de la Ciudad de México: Gabriel Ramírez, Reporteros: Francisco Olascoaga, Roberto Márquez, Marcos Robles, Armando Villa , Alfredo Rendón. Foto grafía: Julio Bautista Columnistas: En la Mira... Gabriel Zendejas, En el Blanco José Luis Belmar, Securitas Et... Agustín V. Siliceo, Este México Nuestro Luis Enrique Martínez, Zona Cero... Javier Divany Bárcenas, El Buzón... Alfredo Ibañez, Sin Línea... José Sánchez López. GRÁFICOS: EDITH HERNÁNDEZ COYOTE COR RESPONSALES: JUAN CARLOS VARGAS MUJICA, CECILIA GALÁN ROMERO, VICENTE GONZÁLEZ PÉREZ, ZORAYA LIZETTE FLORES MEJÍA, GABRIEL ROMERO G., VANESSA ORTÍZ. VENTAS: LUIS ENRIQUE QUINTANA VILLANUEVA, NANCY PINEDA VÁZQUEZ, CONTABILIDAD: CORPORATIVO RIVERA Y ASOCIADOS, DEPAR TAMENTO JURÍDICO: FERNÁNDEZ DE CEVALLOS & PAZ, JEFE DE TALLER: ROBERTO MUNGUÍA GÓMEZ, JEFE DE ROTATIVAS: FIDEL ZAMUDIO, JEFE DE PRENSAS: EDGAR ROJAS. OFICINAS GENERALES: ARIS TÓTELES No. 131 COL. POLANCO C.P. 11560, MÉXICO D.F. TELEFÓNOS: (01 722) 2-07-31-44, 3-18-47-10, 3-18-47-11, MÉXICO D.F.: 0155 2073 7947. DISTRIBUCIÓN: CIUDAD DE MÉXICO, ÁREA METROPOLITANA, ESTADO DE MÉXICO, JALISCO, NAYARIT, COLIMA, BAJA CALIFORNIA, SONORA, QUERÉTARO, PUEBLA, QUINTANA ROO, GUANAJUATO. PERIÓDICO DIARIO DESDE OCTUBRE 11 DE 2004 EDITOR RESPON SABLE: CHRISTIAN GARCÍABELTRÁN CAMACHO; NÚMERO DE CERTIFICADO DE RESERVA INSTITUTO NACIONAL DE DERECHO DE AUTOR: (04-2004-081114191400-01); NÚMERO CERTIFICADO DE LICITUD DE TÍTULO: 13841. NÚMERO CERTIFICADO DE LICITUD DE CONTENIDO: 11414. TIRAJE ESTIMADO: 68,550 EJEMPLARES GRATUITOS. PLANTAS IMPRESORAS: MÉXICO, EJE 1 PONIENTE BUCARELI, JUÁREZ CUAUHTÉMOC, CP. 06400, D.F. PLANTA JALISCO: PERIFÉRICO PTE. No. 4360 COLONIA SAN JUAN DE OCO TAN, ZAPOPAN JALISCO, CP 45019. PUBLICACIÓN IMPRESA POR BRAMI S.A. DE C.V. LAS OPINIONES VER TIDAS EN NOTAS Y COMENTARIOS SON DE EXCLUSIVA RESPONSABILIDAD DE QUIENES LAS EMITEN Y NO REPRESENTAN NECESARIAMENTE LA LÍNEA EDITORIAL. PERIÓDICO EDITADO Y PUBLICITADO POR EL Informante del Centro S.A DE C.V. con dirección Mario Pani 400, Lomas de Santa Fe, Contadero, DEL. CUAJIMALPA, CIUDAD DE MÉXICO SÓLO SE PUBLICARÁN LOS COMENTARIOS RELACIONADOS CON LA NOTICIA Y AQUELLOS QUE CUMPLAN CON EL RESPETO A LAS PERSONAS Y LA DIVERSIDAD DE OPINIONES. SE PROHÍBE EXPRESAMENTE LA REPRODUCCIÓN O COPIA DE LOS CONTENIDOS DE ESTE MEDIO SIN EL EXPRESO CONSENTIMIENTO DE SUS EDITORES Y/O ADMI-NISTRADORES. NOTAS: RESPONSABILIDAD DEL REPORTERO. SUBDIRECTOR DEL VALLE DE
MÉXICO
LIC.
JORGE TREJO MARTÍNEZ
COORDINADOR GENERAL CIUDAD DE MÉXICO MARISOL
MARTÍNEZ M.
DIRECTORA ENLACES GUBERNAMENTALES ROSARIO
ESTRADA T.
COORDINADOR ZONA
ORIENTE
L.A.E.
JUAN
RUEDA RANGEL COORDINADOR DE NOTICIAS ROBERTO RODRÍGUEZ AGUILAR JEFE DE REDACCIÓN SANTOS SÁNCHEZ ALBARRÁN DIRECTOR GENERAL EDOMÉX ALEJANDRO FRANCO MENDIETA DIRECTOR NACIONAL DE EDICIÓN ABRAHAM C. CASTRO CERÓN DIRECTORIO DIRECTOR DE RELACIONES PÚBLICAS ALFREDO OLMEDO DEAN DIRECTORA ADMINISTRATIVA ARACELI SÁNCHEZ GARCÉS PRESIDENTE FUNDADOR +LIC. JAVIER GARCÍABELTRÁN ESTRADA BRAMI S.A. DE C.V. MAGAZINE & TELEVISION MR Un Programa donde te informarás chingón y divertido, exhibiendo a las ratas, analizando accidentes y comentando los videos virales Lunes, Miercoles y Viernes 21:30 PM A través de Facebook Live www.https://www.facebook.com/QuePocaMadreCDMX